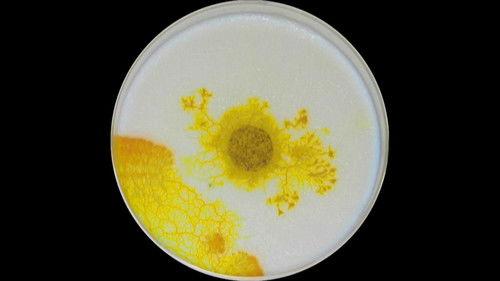
Découverte Season 32 Episode 24 - Episode 24

Episode Rankings
- #1 Fan Favorite
The 20 BEST Episodes of Découverte
READ

Every episode of Découverte Season 32 ranked from best to worst. Discover the Best Episodes of Découverte Season 32!
Charles Tisseyre explores the world of science and technology through real-world stories. Each episode features reports delving into technological breakthroughs and developments in scientific research, environmental issues, space exploration, as well as health and medicine.
"Episode 1" is the best rated episode of "Découverte" season 32. It scored /10 based on 0 votes. Directed by Unknown and written by Unknown, it aired on 9/8/2019. This episode is rated 0.0 points higher than the second-best, "Episode 2".